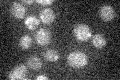
YDR246W

View description
One of 10 subunits of the transport protein particle (TRAPP) complex of the cis-Golgi which mediates vesicle docking and fusion; involved in endoplasmic reticulum (ER) to Golgi membrane traffic; human homolog is TRAPPC4
Localization:
Intensity:
Fold change:
Significance:
-
C’ GFP library in SD

punctate18.91 -
N' NOP1pr-GFP in SD

punctate69.6014 -
N' TEF2pr-mCherry in SD

cytosol61.9639 -
N' NATIVEpr-GFP in SD

punctate35.7948 -
N' TEF2pr-VC and Cyto-VN in SD

below threshold28.2922 -
C’ GFP library in SD+DTT

punctate18.750.99No -
C’ GFP library in SD+H2O2

punctate17.340.91No -
C’ GFP library in Starvation Media
punctate16.560.87No -
C’ GFP library on the background of Pup2-DaMP

punctate -
C’ GFP library on the background of CCT mutant

punctate16.86650.89177No
